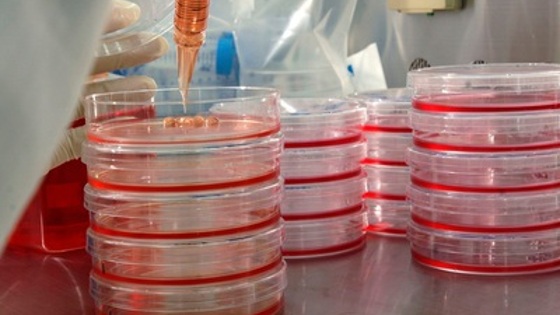

Создано устройство для безопасного сбора стволовых клеток при кесаревом сечении
Амниотическая жидкость, или околоплодные воды, окружающие и защищающие ребёнка в материнской утробе, всегда считалась так называемыми медицинскими отходами. Но после открытия стволовых клеток стало ясно, что этого драгоценного материала в амниотической жидкости содержится очень много (как и в пуповинной крови, например). Напомним, что стволовые клетки ценны для науки тем, что могут бесконечно делиться (даже после смерти человека) и развиваться в любой тип клеток. Это свойство позволяет использовать их в клеточной терапии и регенеративной медицине – для восстановления повреждённых органов и тканей и даже создания их с нуля. Однако современные методы сбора стволовых клеток либо инвазивны, либо болезненны (как в случае с костным мозгом), либо этически противоречивы (например, работа с человеческими эмбрионами), либо "малоурожайны" (как при сборе клеток из пуповинной крови). Потому исследователи разрабатывают новые способы получения стволовых клеток. Один из них представила команда из Лундского университета (Швеция). Это многоэтапный метод сбора и последующей обработки стволовых клеток из амниотической жидкости, для которого потребуется специально созданное устройство. По словам авторов, их метод позволит получать стволовые клетки в больших количествах, причём сбор околоплодных вод будет происходить абсолютно безопасным способом. Кроме того, учёные смогут впоследствии использовать не только стволовые клетки, но и ценные биоактивные молекулы, также содержащиеся в жидкости, окружающей малыша. Специальное устройство, о котором идёт речь, сконструировано из биоинертного пластика с применением технологий трёхмерной печати. Сперва при помощи устройства производится забор большого объёма амниотической жидкости, затем её пропускают через фильтр с микроскопическими ячейками, а после этого жидкость отправляется в специальную центрифугу для выделения мезенхимальных стволовых клеток. Эти клетки ранее уже показали высокий терапевтический потенциал в борьбе с иммунными заболеваниями и воспалительными процессами внутри организма. К примеру, с их помощью можно лечить диабет, артрит, сердечно-сосудистые и нейродегенеративные болезни. Однако их использование ранее было ограничено, так как из других тканей организма этот тип клеток можно выделить лишь в совсем небольших количествах. "Мы показали, что с помощью нашего устройства можно собрать до литра амниотической жидкости в ходе кесарева сечения. Этот процесс продлит операцию всего на 90 секунд и будет безопасен как для матери, так и для ребёнка", — рассказывает ведущий автор исследования Андреас Хербст (Andreas Herbst). Кстати, в научной статье, опубликованной в издании Stem Cell Research & Therapy, команда Хербста пишет о нераскрытом потенциале мезенхимальных стволовых клеток. По мнению исследователей, эти клетки можно преобразовать в эмбриональные стволовые клетки. А из последних можно, как известно, вырастить различные типы клеток организма, включая нервные, клетки крови, сердца и так далее. Следующим шагом учёных из Швеции станет изучение мезенхимальных стволовых клеток и возможностей их преобразования. Авторы также надеются, что их технология после клинических испытаний будет применяться во всём мире – таким образом учёные получат огромное количество стволовых клеток для будущих исследований, а терапия с их использованием станет общедоступной.